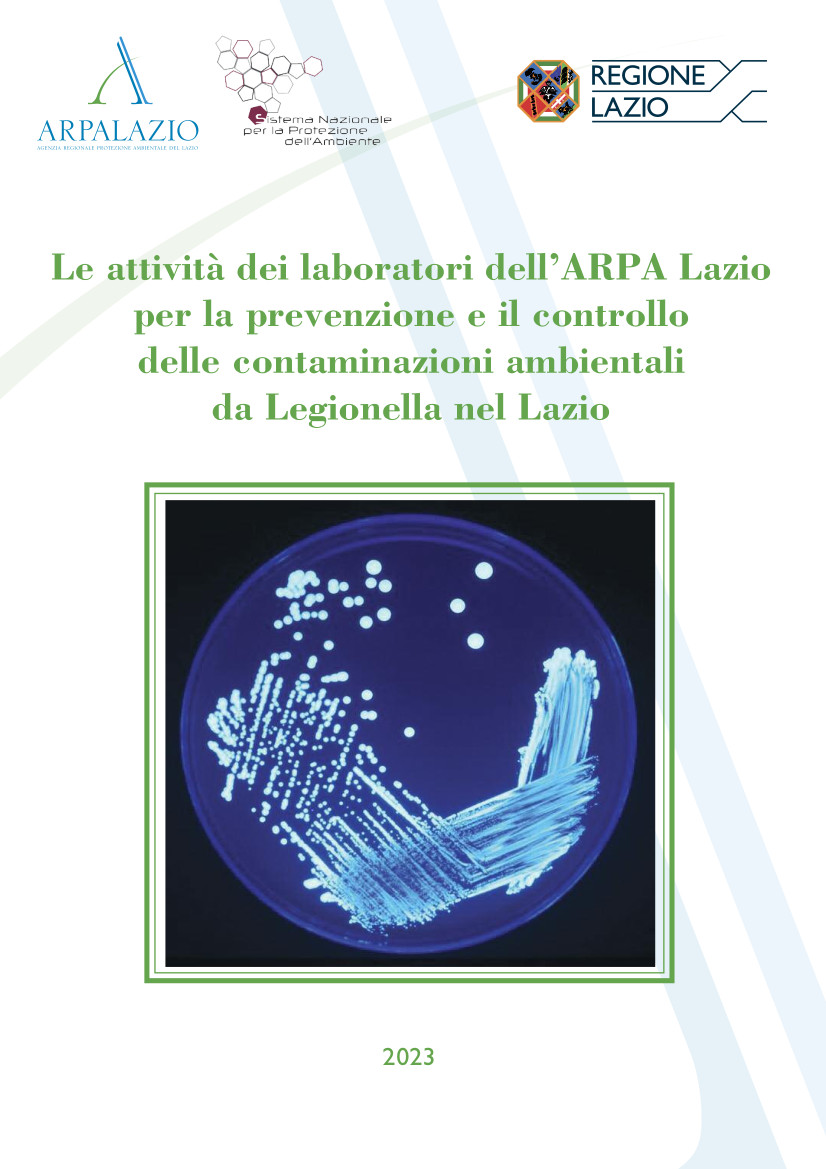

ASL Roma 2
@aslrm2
"Vicini a te, anche con il digitale" - Account ufficiale della #ASLRoma2 - ✍🏻 Iscriviti al nostro canale YouTube per vedere tutte le testimonianze #OpenASL !
ID: 1567240837020401665
https://www.youtube.com/channel/UCPZg-gcD1sSe5Pgsv499Bow 06-09-2022 19:58:56
439 Tweet
367 Followers
273 Following

La storia positiva di inclusione lavorativa di Claudia partita dal centro diurno di Cinecittà del dipartimento di #salutementale ASL Roma 2 nel solco del Festival RO.MENS per l' inclusione sociale contro il pregiudizio. @laurabertitg2 rainews.it/rubriche/tg2me…




Ricerca italiana proposta dal DSM ASL Roma 2 per recuperare la salute mentale dei migranti pubblicata su Communications Medicine di Nature: l'accoglienza attenta ai valori sociali, alle problematiche psicologiche e alla cultura, migliora la #salutementale. nature.com/articles/s4385…

👠 L’intervista di Felicia Pelagalli, PhD a Massimo Cozza 👉 Video integrale: youtu.be/-M_UBP6GkdA?fe… #giornatacontrolaviolenzasulledonne #OpenASL


🔴 Oggi con noi al Sant'Eugenio il Presidente della Regione Lazio #FrancescoRocca ! Dare risposte a chi ha bisogno di #Salute, in uno sforzo attento e comune. #OpenASL Salute Lazio Francesco Rocca



La medicina digitale comporta lo sviluppo di un nuovo paradigma di salute (fare cose nuove, supportati da strumenti nuovi), entro un ecosistema #digitale che presenta vantaggi estremamente concreti. L'articolo del nostro DG #GiorgioCasati su IlSole24ORE 👉s24ore.it/6netGw



📌 In Consiglio regionale premiate le eccellenze sanitarie del Lazio 👉 Il presidente Antonello Aurigemma 🇮🇹 ha consegnato quattro targhe a Cognetti, Casati, Capobianco e Guazzaroni 🔽 Leggi la notizia 🔽 consiglio.regione.lazio.it/?vw=newsDettag…

🔴 🔵 Gli ematologi del Sant’Eugenio e del San Giovanni a casa dei pazienti con patologie invalidanti 👉La notizia su Quotidiano Sanità: quotidianosanita.it/lazio/articolo… Mercoledì #20dicembre in Sala Montalcini Ospedale Sant’Eugenio saranno presentati i risultati dei primi 10 mesi di del progetto



👉Guido Scorza Componente Garante Privacy : "Non c’è e non deve esservi nessun antagonismo tra diritto a innovare, diritto alla #salute e diritto alla #privacy. Dobbiamo trovare la miglior possibile posizione di equilibrio”. 👉Leggi l'articolo su Wired Italia: wired.it/article/intell…


Contaminazioni ambientali da #Legionella nel #lazio, online e scaricabile il nuovo report con le attività dei laboratori #ARPALazio (dati 2022): arpalazio.it/documents/2012… SNPA Consiglio Lazio Salute Lazio Ministero della Salute Agenas